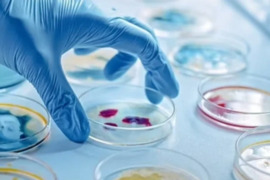
.

Son xəbərlər
Şuşada kamera müşahidəsi aparılır - Şəhəri zibilləyənlər cərimələnəcək
Şuşa Şəhər Dövlət Qoruğu İdarəsi şəhəri ziyarət edən turistlərə müraciət ünvanlayıb. Qurumdan "Qafqazinfo"ya bildirilib ki, işğaldan azad edilən Şuşa şəhərinə turist axını şəhərin çirkləndirilməsinə səbəb olub. Dövlət Qoruğu bununla əlaqədar maarifləndirici video yayıb. Videoda şəhərin zibilləyən
23 avqust 2024
İkiotaqlı ev bir göz qırpımında külə döndü - Hadisə yerindən GÖRÜNTÜLƏR
Avqustun 22-si Zaqatalanın Qımır kəndində yanğın baş verib. Elnur Səmədova məxsus kürsülü ikiotaqlı fərdi yaşayış evində baş verən yanğının söndürülməsi üçün hadisə yerinə Zaqatala Rayon Dövlət Yanğından Mühafizə Hissəsinin texnikası və canlı qüvvəsi cəlb edilib. Yanğın nəticəsində evin 70 kv/m-lik hissəsini
23 avqust 2024
Bəzi ərazilərdə qaz olmayacaq
Avqustun 23-ü saat 08:00-dan "Qaradağ-Sumqayıt" magistral qaz kəmərində görüləcək təmir-quraşdırma işləri, saat 10:00-dan etibarən isə Suraxanı rayonunun Hövsan qəsəbəsi, Məktəbli küçəsində qaz xəttinin yerinin dəyişdirilməsi məqsədilə qaz təchizatının dayandırılması planlaşdırılır. xəbər veri
23 avqust 2024
Şəki sakinlərini boğaza yığan yol PROBLEMİ
Şəkinin Aşağı Layısqı kəndinin sakinləri yol problemindən şikayətçidirlər. Sakinlərin sözlərinə görə, kəndə bir dəfə də olsun asfalt örtüyü salınmayıb və yolun üç kilometrlik hissəsi yararsız vəziyyətdədir. Daşlı-kəsəkli yolda yaranan çalalar avtomobillərin rahat hərəkətinə maneə yaradır. Yağış yağdıqd
23 avqust 2024
Tədris ilinin başlamasına az vaxt QALIB: Məktəbli formalarının satışı necə GEDİR? - VİDEO
Yeni tədris ilinin başlamasına çox az bir vaxt qalıb. Adətən bu ərəfələr valideynlər arasında uşaqları üçün məktəb təlaşı başlayır. Siyahı tutulur və alış-veriş edilir. Bəs hazırda bu mövzu ilə bağlı vəziyyət necədir? . xəbər verir ki, mövzu ilə bağlı İTV-nin əməkdaşları sakinlər arasında sorğu keçirib:
23 avqust 2024
Qeyri-adi təbiət hadisəsi - Səmada 7 Günəş göründü - FOTOLAR
Çində Çenqdu şəhərinin səmasında optik illüziyaya görə 7 günəş görünüb. "World of Buzz"a istinadən xəbər verir ki, nadir təbiət hadisəsi nəticəsində Çin üzərində səmada 7 "günəş" peyda olub. Yerli sakinlərin dediyinə görə, onlar belə mənzərəni ilk dəfə görürdülər. Bildirilib ki, Çenqd
22 avqust 2024
Kadırovun 16 yaşlı oğlu Putinlə fotosunu paylaşdı
Çeçenistan rəhbəri Ramzan Kadırovun 16 yaşlı oğlu Adam Putinin Qroznıya səfəri zamnaı birgə foto çəkdirib. Ölkə.az xəbər verir ki, 16 yaşlı Adam Kadırov Putinlə fotosunu instaqram səhifəsində paylaşıb. Adam Kadırovun prezident Putinlə fotosu təyyarənin yanında çəkilib. Vladimir Putin avqustun Çeçenistan
22 avqust 2024
Yoxsulluğun lənəti: Ailədə olduğunun beş əlaməti və təmizləməyin yolları
Lənətlər və onların həyata təsiri bir çox insanı maraqlandıran mövzudur, hətta onlar ucadan "nə Allaha, nə şeytana, nə də pokerə" inanmadıqlarını söyləsələr də. Bu xüsusilə yoxsulluq məsələsi üçün doğrudur, o zaman ki, pul barmaqlarınızın arasından sürüşür və maliyyə rifahı əlçatmaz görünür
22 avqust 2024
Səttar Möhbalıyev İSTEFA VERDİ
Avqustun 22-də Azərbaycan Təhsil İşçiləri Azad Həmkarlar İttifaqı Respublika Komitəsinin (ATİAHİ Respublika Komitəsi) II Məclisi keçirilib. xəbər verir ki, ATİAHİ-nin sədri Səttar Möhbalıyevin sədrliyi ilə keçirilən iclasda Məclisin gündəliyi təsdiq edilib. İclasda təşkilati məsələyə baxılıb. Məclisd
22 avqust 2024
Putin QURANI öpdü - VİDEO
Rusiya prezidenti Vladimir Putin son 13 ildə ilk dəfə Çeçenistana gedib. xəbər verir ki, səfər zamanı insanları ən çox təəccübləndirən nüans Putinin "Quran-i Kərim"i öpməsi olub. Buna cavab olaraq Kadırov Putinə əl istehsalı dəbdəbəli Quran və "Çeçenistan Respublikasının fəxri vətəndaşı"
22 avqust 2024
"10 il sonra milyonlarla insanın beynində çip olacaq"
"Gələcək 10 ildə milyonlarla insan Neuralink beyin implantlarından istifadə edəcək". "Qafqazinfo" xəbər verir ki, bu barədə məlumatı "Neuralink" şirkətinin sahibi, amerikalı milyarder İlon Mask "X" hesabında paylaşıb. "Əgər hər şey yaxşı getsə, bir neçə i
22 avqust 2024
Dünyada ən çox qızıl ehtiyatına malik ölkələr - SİYAHI
Beynəlxalq Qızıl Şurası dünya ölkələrinin qızıl ehtiyatları barədə məlumatları yeniləyib. AZƏRTAC xəbər verir ki, qızıl ehtiyatlarına görə liderlik edən ölkələrin rezervləri son bir ildə ciddi dəyişikliyə uğramayıb. Banklardakı qızıl ehtiyatının həcminə görə ilk yerdə 8 133 tonla ABŞ gəlir. Növbəti pilləd
22 avqust 2024
Viktoriya Bekhem haqqında sənədli serial çəkiləcək
"Netflix" platforması keçmiş "Spice Girls" ulduzu Viktoriya Bekhem haqqında sənədli serial hazırlayır. xəbər verir ki, bu barədə "Variety" məlumat yayıb. Bioqrafik serial məşhurun 90-cı illərdəki musiqi karyerasından moda sənayesindəki hazırkı işinə qədər olan səyahətin
22 avqust 2024
Azərbaycanda bir qrup tələbə narazıdır - "Yeni qərar bizə şamil edilməsin" - AÇIQLAMA
Mingəçevir Dövlət Universitetinin Menecement fakültəsinin tələbələri narazıdırlar. Bu barədə çox sayda şikayət -in "qaynar xətti"nə daxil olub. Bildirilib ki, buna səbəb tələbələr əyani təhsil formasını qiyabiyə çevirmək istəyən zaman qarşılaşdıqları çətinlik olub. Tələbələr bildirirlər ki
22 avqust 2024
Timsah çay kənarında qab yuyan qadını yeyib
İndoneziyada çayda 54 yaşlı qadın timsahın hücumuna məruz qalıb. xarici mediaya istinadən xəbər verir ki, öldürülən timsahın içərisində parçalanmış qadının qalıqları tapılıb. Ölkədə 14 timsah növü yaşayır və yaşayış yerlərinin itirilməsi səbəbindən kəndlərə yaxınlaşırlar. İnsanların gündəlik olaraq çaylarda
22 avqust 2024
Kirayə mənzil axtaran tələbələri gözləyən problem - Bu evlərin qiyməti bahalaşacaq
"Ağ şəhərdə iki otaqlı, 70 kv.m məzilin kirayə qiyməti 2 min manatdır. 28 may, Təbriz küçəsində iki otaqlı mənzillərin qiyməti isə 1200-1500 manat arasında dəyişir. Belə mənzillər tələbələr üçün əlçatan deyil". Bunu Qaynarinfo-ya açıqlamasında mənzil eksperti Ramil Osmanlı deyib. Ekspert b
22 avqust 2024
Tehran Qərblə münasibətlərin qurulmasının şərtini açıqladı
Tehran ölkə iqtisadiyyatına qarşı sanksiyaların ləğvi və onun beynəlxalq ictimaiyyətlə normal ticarət əlaqələrinə qaytarılması istiqamətində mühüm addım kimi, İran Xarici İşlər Nazirliyi Vaşinqtonla gərginliyi aradan qaldırmağa və Avropa ölkələri ilə əlaqələri bərpa etməyə çalışacaq. Ölkə.Az xəbər veri
22 avqust 2024
Yerüstü parkinqdə bir saatdan beş dəqiqə keçəndə niyə iki saatın pulu tələb olunur?
Bakıda yerüstü pullu parklanma ərazisində ödəniş qaydalarının ədalətli təyin olunmaması ətrafında sosial şəbəkələrdə müzakirələr aparılır. xəbər verir ki, sürücülər parkinq ərazisində bir saatdan beş dəqiqə artıq dayanmalı olanda birbaşa iki saatın pulunu ödəmək məcburiyyətində qaldıqlarından şikayə
22 avqust 2024
DİQQƏT: COP29 bəzi ixtisaslarda bal artımına səbəb ola bilər - RƏSMİ
"COP29 bəzi ixtisaslarda bal artımına səbəb ola bilər". -ın məlumatına görə, bunu Dövlət İmtahan Mərkəzinin İdarə Heyətinin sədri Məleykə Abbaszadə deyib. "Müsabiqə ballarının dəyişməsi bir növ həmin il tələbələrin maraqlarının artdığı, cari ildə dəbə düşən ixtisaslardan da asılıdır. B
22 avqust 2024
Sabah bəzi ərazilərdə qaz olmayacaq
Avqustun 23-ü saat 08:00-dan "Qaradağ-Sumqayıt" magistral qaz kəmərində görüləcək təmir-quraşdırma işləri, saat 10:00-dan etibarən isə Suraxanı rayonunun Hövsan qəsəbəsi, Məktəbli küçəsində qaz xəttinin yerinin dəyişdirilməsi məqsədilə qaz təchizatının dayandırılması planlaşdırılır. xəbər veri
22 avqust 2024
Alimlər Yer kürəsində ilk canlı hüceyrələrin yaranmasının sirrini açıblar
Hyuston və Çikaqo universitetlərinin (ABŞ) alimləri belə qənaətə gəliblər ki, Yer kürəsində ilk canlı hüceyrələr yağışlar sayəsində əmələ gəlib. Bu proses təxminən 3.8 milyard il əvvəl baş verib. xəbər verir ki, bu barədə müvafiq araşdırma "Science Advances" elmi jurnalında dərc olunub. Araşdırm
22 avqust 2024
Xüsusi nəfəsalma üsulu şiddətli ağrıları yüngülləşdirə bilər?
20 dəqiqəlik tənəffüs seansı xərçəng ağrılarının və narahatlığının intensivliyini azalda bilər. xəbər verir ki, bunu "BMJ Supportive & Palliative Care" jurnalında dərc olunan araşdırma göstərib. Tədqiqatçılar müxtəlif növ xərçəngdən əziyyət çəkən 40 xəstəni iki qrupa ayırıblar. İştirakçıları
22 avqust 2024
Məşhur türkiyəli aktyor məhkəməyə verilir
Məşhur türkiyəli aktyor Kadir Doğulu məhkəməyə verilə bilər. Bu barədə " "a istinadən xəbər verir. Məlumata görə, aktrisa Neslihan Atagüllə xoşbəxt evliliyik yaşayan və ata olmağa hazırlaşan aktyor iqtisadi çətinlik səbəbindən prodüser şirkətinin ofisini bağlayıb. İşdən çıxarılan və üç aydı
22 avqust 2024
Kriştianu Ronaldu tualetə getdiyi üçün cəzalandırılacaq
"Ən-Nəsr"in hücumçusu Kriştianu Ronaldunun Səudiyyə Ərəbistanı superkubokunda komandasının məğlubiyyətindən sonra ikinci yer üçün medalını almağa getməkdən imtina etdiyinə görə cəzalandırılacaq. xəbər verir ki, Kirştianu Ronaldu ikinci yeri almamaq üçün tualetə getdiyini bəhanə edib. Səudiyy
22 avqust 2024
Xoşbəxtliyi pulla almaq olar? - Elm adamları sınaqdan keçirdi
Tanınmış bir həqiqətə görə, pul xoşbəxtliyi satın ala bilməz, lakin hər şeyə şübhə etməyə vərdiş edən elm adamları bu ifadəni sınamağa qərar veriblər. Ola bilsin ki, bu, sadəcə olaraq yoxsul və ya orta təbəqə üçün bir deyimdir. xarici KİV-ə istinadən xəbər verir ki, bu məsələ üzərində Pensilvaniya Universitetini
22 avqust 2024
""Mayka"nı ayağıma geyinirəm" - VİDEO
Müğənni Namiq Qaraçuxurlunun açıqlaması marağa səbəb olub. xəbər verir ki, keçmiş söz ustasının "Xəbər-ətər" verilişində dediyi sözlər gülüş doğurub. Beynində işlərin çox olduğundan gileylənən sənətçi hətta, çaşıb "mayka"nı ayağına geyindiyini etiraf edib. Otağın qapısını açmaq yerinə
22 avqust 2024
Hüseyn Dərya kimdir? – 5 dəfə intihara cəhd edən, sui-qəsdə məruz qalan cəhənnəm əhli
"Bioqrafiya" rubrikasında az ömrünə çox faciələr sığdırmış, gənc yaşında vəfat edən, özünü sağlığında belə cəhənnəm əhli adlandıran reper Hüseyn Dəryadan bəhs edir. - Hüseyn Dərya nə zaman və harada anadan olub?. Hüseyn Dərya 1975-ci il iyunun 29-da Suraxanı rayonunun Bakıxanov qəsəbəsind
22 avqust 2024
Qadınlara qarşı amansızlığı ilə dünyanı silkələyən, 53 nəfərin qatili olan Andrey Çikatilo
Baku TV uşaqlığı və gəncliyi boyu alçaldılan və lağa qoyulan, fərziyyələrə görə 78, təsdiqlənmiş məlumatlara görə isə 53 nəfərin qatili olan SSRİ dövrünün ən qəddar və qanlı manyaklarından biri olan Andrey Romanoviç Çikatilo haqqında araşdırma təqdim edib. Çikatilo ilk qətlini 22 dekabr 1978-ci ild
22 avqust 2024
100 dəfədən çox evləndilər: Evli cütlüyün qeyri-adi rekordu
ABŞ-da maraqlı rekorda imza atan cütlük var. Belə ki, David və Lauren Blair yüz dəfədən çox evlənib. Maraqlısı isə onların heç vaxt boşanmadıqları, sadəcə olaraq toy mərasimlərini yenidən təşkil etdikləridir. David və Lauren Blair toylarını necə keçirirlər?. İldə bir neçə dəfə evlənirlər, hər mərasim
22 avqust 2024
"Bir-birimizə halallıq vermişik, Emilin üç mərasimi günü gəlib mənə sual verdilər ki..."-Sabrina əsəbləşdi-FOTO
"Emildən sonra toparlanmışam, ayaqda durmağa çalışıram. İşlərimlə məşğulam. Amma Emilin adı, havası gələndə çox pis oluram. Hər dəfə istər gecə, istərsə də gündüz vaxtı evə Emillə gəlirdim. İndi onsuz evə keçəndə özümü pis hiss edirəm. Amma həyat davam edir. Hərəmiz kimin üçünsə yaşayırıq. Ona gör
22 avqust 2024
Borclu şəxs qismində axtarışda olan 76 nəfər saxlanılıb
Yüksək təzyiq zamanı nə yemək olmaz? - Ən zərərli 8 məhsul
Metronun yeni stansiyası AÇILACAQ - BU TARİXDƏ
Bu gecədən Kiçik çillə başlayır: şaxta, çovğun və sərt günlər...
Həmin gün bayram olsa da, İŞƏ GEDƏCƏYİK
Pensiya və əməkhaqqı ilə bağlı vacib AÇIQLAMA
Bakıda hava bu tarixdə KƏSKİN DƏYİŞİR: QAR YAĞACAQ
XƏBƏRDARLIQ: Türkiyədən güclü qar fırtınası Azərbaycana doğru gəlir: Bu tarixdə HAVA KƏSKİN DƏYİŞƏCƏK
2 fevralda iş olacaq?
Arne Slot "Liverpul"un oyunçusu ilə soyunub-geyinmə otağında dalaşıb
Xəzər çəkildi, qəbirlər üzə çıxdı - 2040-cı ilə qədər...
Bu məbləğdə pensiya alanlara artımla bağlı ŞAD XƏBƏR
Fatih Ürek vəfat etdi
"Oğlum bir ömür həbsxanada sürünsün" - Baltalanan qadının qayınanası
Qar yağacaq, külək güclənəcək - SON DƏQİQƏ XƏBƏRDARLIĞI
